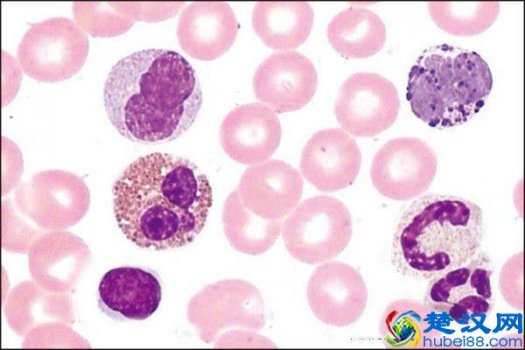
尿白细胞偏高的原因有哪些，需要注意哪些方面！

专业IT网络知识平台,分享IT百科知识、生活百科知识解答!

c语言的输入函数有哪些...浏览:766次
奇异值分解(SVD)简介及其在图片压缩中的示...浏览:1927次
用U盘轻松实现一键重装系统的小白装机教程浏览:5545次
因特网能提供的最基本服务有哪些浏览:4453次
某台微机安装的是64位操作系统中,64位指的...浏览:9933次
总结CreateJS的详细介绍浏览:4816次
ppt中怎么插入自定义动作按钮浏览:9735次
c语言是什么意思浏览:1576次
主板显卡卡扣断了怎么办浏览:301次